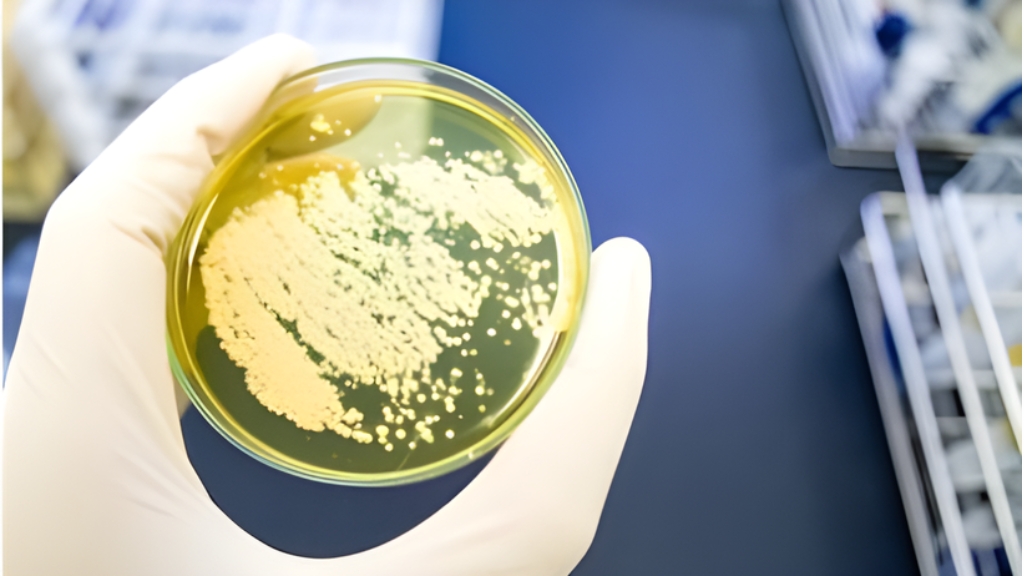

Pioneering the future of industrial biotechnology, Valient Biotech is redefining the science of fermentation, water innovation, and sustainable solutions. Driven by cutting-edge research and transformative technologies, we transcend conventional boundaries to deliver higher efficiency, unmatched resilience, and a cleaner, sustainable tomorrow.

Optiferm CWR
At Valient Biotech, we have pioneered Optiferm CWR, a specialized innovation for evaporation condensate water recycling in fermentation. Unlike conventional treatments, Optiferm CWR enables direct reuse of condensate water without the need for costly CPU or RO systems. It ensures clean, efficient, and sustainable water recovery, reduces operational costs, and supports industries in achieving 50–60% recycling efficiency. By controlling contamination and improving fermentation quality, Optiferm CWR is setting new benchmarks in sustainable distillery operations.

Neutriozyme CT
We have developed Neutriozyme CT, a multi-functional single solution that
redefines cooling tower management. This advanced product not only tackles scale, corrosion, and microbial growth but also performs reliably in high-COD water conditions where traditional chemicals fail. By enabling the direct recycling of spent lees and biomethanated condensate water, Neutriozyme CT extends system life,
lowers maintenance costs, and enhances overall plant efficiency. It’s more than just a chemical—it’s a complete innovation for sustainable cooling water management.

Valient Bio-ADY
Valient Biotech has introduced Valient Bio-ADY, a premium active dry yeast formulated for robust, consistent, and high-yield fermentation performance. Designed to withstand stress conditions in molasses and grain-based distilleries, it delivers faster starts, stable fermentation cycles, and superior alcohol yields. With improved tolerance to inhibitors and excellent viability, ensures predictable results batch after batch. This innovation empowers distilleries to maximize efficiency while ensuring process stability, productivity, and profitability.
Vproxyl
With Vproxyl, we have innovated a powerful antimicrobial solution tailored
specifically for sugar processing and ethanol fermentation. It delivers precise and effective bacterial control, reducing volatile acids and preventing contamination that can disrupt fermentation efficiency. By safeguarding ethanol yield and improving process reliability, Vproxyl ensures a cleaner, smoother, and more efficient fermentation process. Its advanced formulation represents Valient Biotech’s commitment to performance-driven, sustainable fermentation solutions.
Experience pioneering innovations that redefine efficiency, performance, and sustainability across industries.
Join us in shaping the next era of industrial biotechnology.

